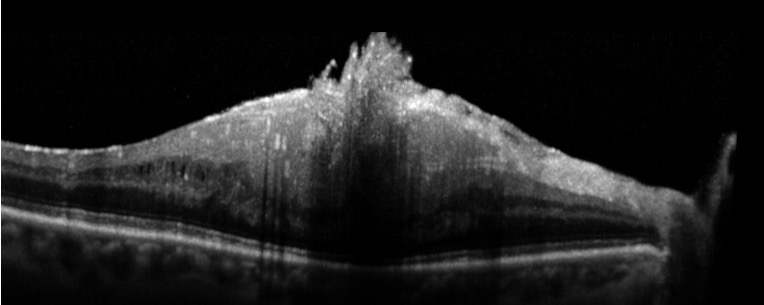

OCT du segment postérieur
dans les pathologies chirurgicales
Introduction
L’amélioration de la définition des OCT, notamment avec la technologie Spectral Domain, permet de segmenter facilement les différentes couches rétiniennes, de la membrane limitante interne à la membrane de Bruch. De plus, l’imagerie en trois dimensions (3D), en plein essor, apporte des informations complémentaires, ce qui nous permet d’affiner le diagnostic étiologique et d’avoir un suivi plus précis de l’anatomie rétinienne. Cet article présente l’apport de l’OCT pour la prise en charge des pathologies maculaires les plus fréquentes.
L’OCT dans les membranes épirétiniennes et les syndromes de traction vitréo-maculaire
L’augmentation de la définition permet de visualiser les membranes épirétiniennes infracliniques
On peut ainsi visualiser les membranes épirétiniennes (MER) même lorsqu’elles sont très fines, ce qui permet de les trouver plus fréquemment. La plupart du temps, ces fines MER ne modifient pas l’anatomie fovéolaire et sont asymptomatiques. Elles ne requièrent donc pas de prise en charge chirurgicale.
Les signes qui peuvent expliquer une baisse visuelle en rapport avec une MER (figures 1 et 2) sont représentés par :
- la perte de la dépression fovéolaire,
- l’augmentation de l’épaisseur rétinienne,
- la déstructuration des couches rétiniennes,
- une altération de la couche des photorécepteurs,
- et des contractions de la MER à la surface de la rétine visualisées sur l’OCT en face.
L’intérêt d’une reconstruction 3D est surtout perceptible dans les pathologies vitréo-rétiniennes tractionnelles en montrant les rapports entre le vitré et la rétine. Elle offre aussi un support pour expliquer la chirurgie et informer le patient. Cet outil reste cependant peu utilisé pour faire le diagnostic (figure 3).
L’OCT en face différencie les pseudo-trous maculaires des trous lamellaires (figure 4)
En préopératoire, l’OCT en face visualise bien les contractions qu’exerce la membrane à la surface de la rétine. Ces contractions peuvent être centripètes entraînant un pseudo-trou maculaire avec des bords verticaux réguliers. Elles peuvent aussi être en rapport avec plu- sieurs épicentres entraînant un étirement de la fovéa. Dans ces deux cas, la chirurgie permet une amélioration fonctionnelle et anatomique [1].
Ces situations sont à différencier d’un trou lamellaire qui est la résultante d’un arrachement des couches internes de la fovéa dans les suites d’un décollement posté- rieur de la hyaloïde. L’OCT en face confirmera l’absence de contractions à la surface de la rétine. Il n’y a pas d’indication opératoire dans les trous lamellaires car elle n’apporterait pas d’amélioration.
L’OCT dans les trous maculaires
L’OCT permet dans un premier temps de faire facilement le diagnostic de trou maculaire. Il est important de réaliser une cartographie maculaire (ou mapping) avec de multiples coupes resserrées pour bien évaluer le stade du trou (figure 5).
La mesure de la largeur du trou maculaire se fait au « collet » sur la coupe où l’ouverture est maximale. Les trous de petite taille (< 150 microns) peuvent se fermer spontanément et un contrôle à un et deux mois peut être proposé avant de réaliser une chirurgie (figure 6).Les trous de moins de 400 microns ne nécessitent pas systématique- ment de pelage de la membrane limi- tante interne et le positionnement postopératoire « face vers le sol » recommandé pourrait être évité [3].
L’OCT en face visualise facilement les modifications entraînées par un pelage de la
membrane limitant.
Le pelage de la limitante interne est fréquemment réalisé durant les chirurgies maculaires. Il est cependant suspecté de ne pas être anodin pour la fonction visuelle, notamment en entraînant des microscotomes postopé- ratoires [2]. L’OCT en face permet de visualiser de petits defects (ou DONFL), au niveau des fibres optiques, qui sont consécutifs à ce pelage (figure 7).
L’OCT dans le fovéoschisis du myope fort
Devant une baisse visuelle inexpliquée chez un myope fort (fond d’œil et angiographie rétinienne normaux), l’OCT devra toujours être réalisée pour rechercher un schisis du myope fort. La dissociation des couches rétiniennes Il n’y a pas de corrélation précise entre les anomalies est due aux tractions opposées qui sont exercées sur la observées sur l’OCT et la baisse d’acuité visuelle. L’indirétine du fait de l’allongement du globe oculaire, d’une cation chirurgicale sera donc retenue après avoir confronté part, et par la présence d’anomalies de l’interface vitréo- l’iconographie à la symptomatologie fonctionnelle et son rétinienne, d’autre part évolutivité (figure 8).
L’OCT pour porter une bonne indication chirurgicale d’un hématome maculaire
Un hématome maculaire peut compliquer une DMLA et entraîner une baisse d’acuité visuelle avec un scotome central important. Si cette hémorragie est récente (< 15jours), elle peut bénéficier d’une chirurgie qui aura pour but de déplacer l’hématome en rétine inférieure. L’OCT va chercher à localiser l’hématome par rapport à l’épithélium pigmentaire. Un hématome principalement sous-rétinien (et non sous l’épithélium pigmentaire) représentera une bonne indication opératoire (figure 9).
